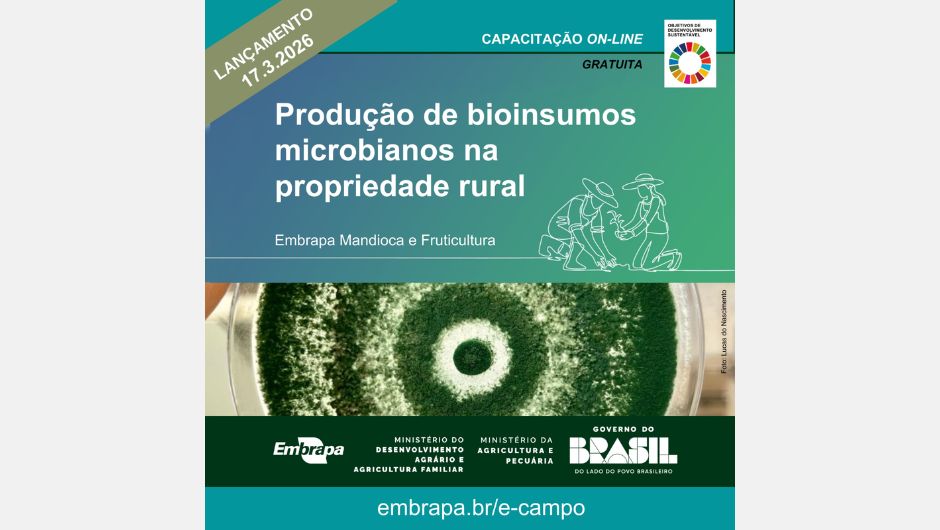

Expodireto Cotrijal 2026 encerra reforçando protagonismo do agro
Feira reuniu 613 expositores, apresentou inovações tecnológicas e ampliou debates sobre endividamento
A Embrapa lança, nesta terça-feira (17/3), o seu novo curso on-line e gratuito “Produção de bioinsumos microbianos na propriedade rural". A apresentação será feita durante a Feira Nacional de Máquinas e Tecnologias para a Agricultura Familiar, em Campinas (SP).
A capacitação é voltada para agricultores familiares, cooperativas rurais e agentes de assistência técnica e extensão rural, e visa a compreensão e aplicação dos fundamentos técnicos, práticos e legais necessários para produzir e utilizar bioinsumos microbianos de forma segura, eficiente e sustentável nas próprias propriedades rurais. Com três módulos e um total de 12 horas, a trilha educativa foi idealizada para ser feita sem tutoria e de forma assíncrona na plataforma E-Campo, permitindo ao participante acessar o conteúdo quando tiver disponibilidade.
O conteúdo programático prevê temas relacionados a multiplicação de microrganismos na propriedade, a nova lei de bioinsumos e o que ela muda na prática, além das seguranças, benefícios e cuidados na produção dentro da propriedade para consumo próprio. Os módulos serão liberados por semana, primeiro no lançamento e os demais nas semanas seguintes.
"Ao final do curso, esperamos que o participante seja capaz de identificar os conceitos básicos sobre microrganismos benéficos, suas funções no solo e nas plantas e os princípios técnicos para sua multiplicação e uso prático no sistema de produção rural; relacionar os principais pontos da legislação que orienta e regula a produção, o uso e a responsabilidade sobre bioinsumos produzidos na propriedade rural, além de reconhecer os principais benefícios do uso de bioinsumos na agricultura familiar e identificar os cuidados, proibições e boas práticas exigidas pela legislação para garantir uma produção segura, eficaz e dentro das normas legais", pontua o pesquisador Harllen Alves, coordenador técnico do projeto.
O curso foi elaborado pela Embrapa Mandioca e Fruticultura (BA), em parceria com o Ministério do Desenvolvimento Agrário e Agricultura Familiar (MDA), e tem como gestora a técnica Olga Lins, do Setor de Gestão de Transferência de Tecnologia. Os demais conteudistas são o pesquisador Fernando Haddad e o analista Leandro Rocha.

Receba por e-mail as últimas notícias sobre agricultura